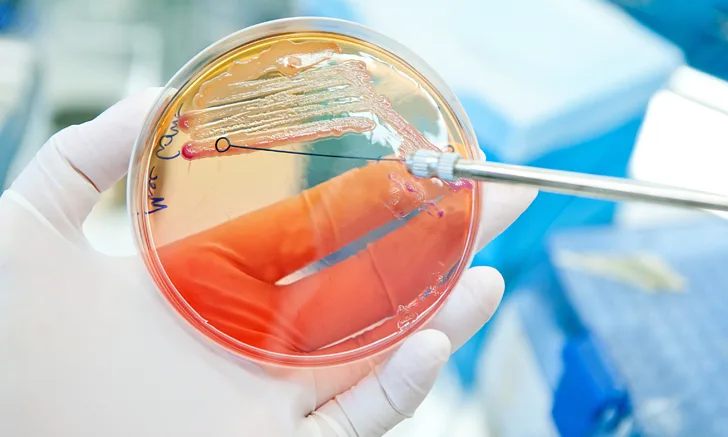

In the Literature
Seidel EJ, Hess RS, Cole SJ, McClosky ME. Clinical differences in enterococcal bacteriuria compared with other bacteriuria in cats. J Feline Med Surg. 2022;24(12):e546-e550. doi:10.1177/1098612X221123767
The Research …
Enterococcus spp are a common isolate in both clinical and subclinical bacteriuria in humans, dogs, and cats and have questionable clinical significance.1 Despite the frequency of Escherichia coli and Enterococcus spp coinfection in canine UTIs, if or how these coinfections impact clinical presentation and outcomes of dogs and cats with polymicrobial UTIs remains unclear. The nonenterococcal organism is anecdotally targeted for treatment by some clinicians, based on an assumption that treatment of the more pathogenic bacteria may lead to resolution of clinical signs or bacteriuria.
In this retrospective case-controlled study, cats with enterococcal bacteriuria (n = 47) were compared with control cats with nonenterococcal bacteriuria (n = 77). Control cats were more likely to have lower urinary tract signs (eg, gross hematuria). Cats with enterococcal bacteriuria were more likely to have subclinical bacteriuria and polymicrobial infections.
This study was not designed to investigate prior antibiotic use in enterococcal cases or controls. Many commonly administered antibiotics (eg, cephalosporins, fluoroquinolones) are not active against Enterococcus spp. Prior exposure to these antibiotics could select for Enterococcus spp as persistent pathogens in the urine, possibly increasing the risk for Enterococcus spp bacteriuria.
… The Takeaways
Key pearls to put into practice:
The significance of Enterococcus spp colonization in the development of lower urinary tract infections in dogs, cats, and humans is unclear. Antimicrobial therapy may not be indicated in subclinical cases. Careful assessment of clinical signs, urinalysis results, and pet owner observations should inform decisions to treat or monitor.
The role of Enterococcus spp infection in subsequent development of other organism infections is unclear. If there is a relationship between presence of Enterococcus spp and later polymicrobial infection or between chronic subclinical inflammation and development of feline interstitial cystitis, Enterococcus spp could have a significant impact on clinical presentation and quality of life. Regular evaluation of the lower urinary tract in these patients is critical for treatment planning.
Imprudent use of antimicrobials, including use of antimicrobials not active against Enterococcus spp (eg, long-acting cephalosporins, commonly prescribed fluoroquinolones), without adequate diagnostic indications may result in Enterococcus spp colonization with potential sequelae. Understanding appropriate antimicrobial use is a key component of antimicrobial stewardship and is required to establish benchmarks, identify areas for improvement, and develop interventions that do not jeopardize patients.2
You are reading 2-Minute Takeaways, a research summary resource presented by Clinician’s Brief. Clinician’s Brief does not conduct primary research.